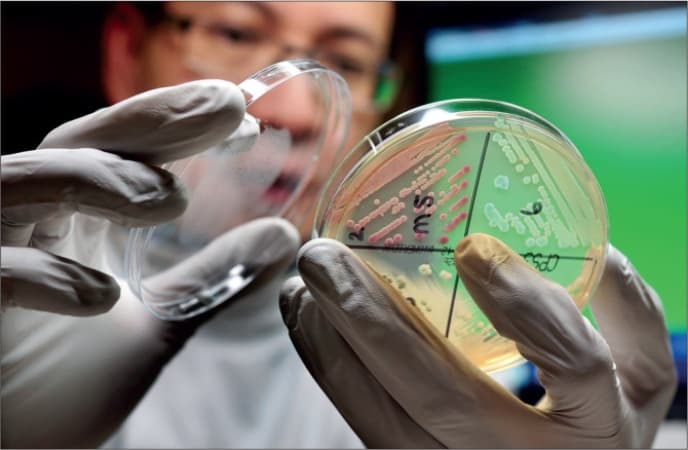
Scientists find potential new antibiotic for treating gonorrhoea

Updating your news feed...

NEWS EXPRESS is Nigeria’s leading online newspaper. Published by Africa’s international award-winning journalist, Mr. Isaac Umunna, NEWS EXPRESS is Nigeria’s first truly professional online daily newspaper. It is published from Lagos, Nigeria’s economic and media hub, and has a provision for occasional special print editions. Thanks to our vast network of sources and dedicated team of professional journalists and contributors spread across Nigeria and overseas, NEWS EXPRESS has become synonymous with newsbreaks and exclusive stories from around the world.

Gepotidacin, newly-discovered antibiotic for treating malaria
Scientists believe they have found a new effective antibiotic for gonorrhoea, which could be one of the most promising in decades.
Gepotidacin can treat and clear the sexually transmitted infection just as well as existing antibiotics and appears to be able to tackle some emerging drug-resistant 'superbug' strains too, say researchers in The Lancet journal.
The work was funded by pharmaceutical company GSK which makes the new tablets.
Gonorrhoea is one of the most common STIs in the UK and cases have been rising.
In 2023, over 85,000 gonorrhoea diagnoses were reported in England alone - the highest number since records began in 1918.
Most of the cases were treatable, but there is growing concern that some strains can't be dealt with so easily.
Over time, the bacterium has developed resistance to most classes of available antibiotics and experts fear it may become untreatable in the future, unless new drugs are found.
Untreated gonorrhoea can lead to serious health issues, including pelvic inflammatory disease and infertility.
Gepotidacin works differently to other antibiotics and stops gonorrhoea from replicating by blocking two essential enzymes.
It's already approved in the US for treating urinary tract infections.
The trial, being presented at the ESCMID conference, involved 628 patients randomly allocated to receive Gepotidacin or an existing antibiotic.
The new pill was equally effective for treating gonorrhoea and worked against strains of the infection that were resistant to current first-line treatments, such as ceftriaxone.
Side-effects were reported more frequently with gepotidacin, but they were generally mild, such as nausea or some stomach discomfort.
Gepotidacine is not the only new oral antibiotic for gonorrhoea that researchers are exploring.
Another, called zoliflodacin, has also shown promise in phase 3 clinical trials.
Meanwhile, the UK is considering a vaccine to help stop the spread of gonorrhoea.
In November 2023, the Joint Committee on Vaccination and Immunisation (JCVI) recommended a targeted roll-out of the MenB vaccine.
Primarily designed to tackle Meningitis B in children, the JCVI found the treatment was roughly 40% effective at preventing people from contracting and spreading gonorrhoea.
Dr Katy Sinka, consultant epidemiologist and head of the STI section at UK Health Security Agency, said it was "really promising" to see a successful trial for a new antibiotic to treat gonorrhoea.
"As gonorrhoea becomes increasingly resistant to antibiotics, it could become untreatable in future and cause serious problems like pelvic inflammatory disease and infertility. Trials like this are so important to help us discover new treatment options."
She said the best way to prevent an STI is by using a condom. If someone has had condom-less sex with a new or casual partner, they should get tested.
"Early detection not only protects a person's health but prevents transmission to others. Testing is quick, free and confidential," she said.
Gonorrhoea: quick facts courtesy of NHS
Gonorrhoea is easily passed from person to person through unprotected sex
Around one in 10 infected men and almost half of infected women do not experience any symptoms
The infection can be passed from a pregnant woman to her baby, and without treatment, can cause permanent blindness for a newborn baby
It is not spread by non-sexual contact like hugging
It is not transmitted through surfaces and materials like toilet seats, towels, cups or plates
If you've had successful treatment for gonorrhoea before, you can still catch it again
(Sourced from BBC, but headline rejigged)